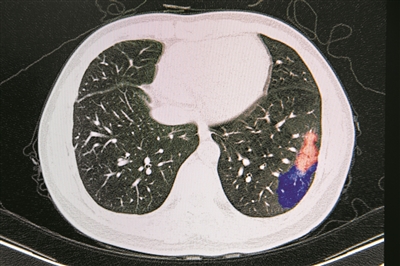

|
ÅVų▌╚²┤¾┐Ų╝╝æ“ę▀”│╔╣¹┴┴ŽÓ░l▓╝Ģ■ AI▌oų·į\öÓ╦«ŲĮ ŽÓ«öė┌Ė▒Į╠╩┌
ĪĪĪĪū“╚šŽ┬╬ńŻ¼ÅV¢|╩Ī╚╦├±š■Ė«ą┬┬ä▐k╣½╩ę┼eąąą┬┬ä░l▓╝Ģ■ĪŻÅVų▌╚²┤¾ė▓║╦┐Ų╝╝│╔╣¹┴┴ŽÓ▒Š┤╬░l▓╝Ģ■Ż║ą┬╣┌▓ĪČŠ╩▄¾wACE2ąĪ╩¾äė╬’─Żą══©▀^┼▀╠źĖ╔╝Ü░¹│╔╣”Į©┴óŻ¼īó½@Ą├╠žČ©ąĪ╩¾─Żą═Ą─ĢrķgÅ─═©│ŻĄ─6éĆį┬┐sČ╠ĄĮ35╠ņŻ╗č╩╩├ūė▓╔śėÖCŲ„╚╦ŽĄĮy▓╔ė├╚╦╣żųŪ─▄ÖCŲ„╚╦▀Mąąč╩╩├ūė╚ĪśėŻ¼▒Żūoßtūo╚╦åT▒▄├ŌĮ╗▓µĖą╚ŠŻ╗AI║Y▓ķ║═▌oų·į\öÓŽĄĮy┐╔Ė∙ō■╗╝š▀ė░Ž±▀MąąųŪ─▄┐ņ╦┘į\öÓŻ¼▓ó─▄┼ąČ©ą┬╣┌Ę╬čūĄ─Ęų╝ē║═ć└ųž│╠Č╚Ż¼┐é¾w£╩┤_┬╩▀_ĄĮ95%ĪŻ ĪĪĪĪ╬─/ÅVų▌╚šł¾╚½├Į¾wėøš▀ĘĮŪńĪóÅłµŁŃ³ĪóÅłŪÓ├Ę ĪĪĪĪłD/ÅVų▌╚šł¾╚½├Į¾wėøš▀╠K┐ĪĮ▄ĪóĘĮŪńĪóÅłµŁŃ³ĪóÅłŪÓ├Ę ĪĪĪĪ▓┐Ęųę▀├ń╝┤īó▀M╚ļäė╬’╣źČŠ▒Żūoįć“× ĪĪĪĪ╩Ī┐Ų╝╝ÅdĖ▒ÅdķL²Åć°ŲĮĮķĮBŻ¼ÅV¢|Š█Į╣┼R┤▓Š╚ų╬║═╦Ä╬’Īóę▀├ńčą░lĪóÖz£y╝╝ąg║═«aŲĘĪó▓ĪČŠ▓ĪįŁīW║═┴„ąą▓ĪīWĪóäė╬’─Żą═śŗĮ©Ą╚╬Õ┤¾ų„╣źĘĮŽ“Ż¼ęį┼R┤▓Š╚ų╬×ķ║╦ą─ī¦Ž“Ż¼┐Ųčą╚╦åTĀÄĘųŖZ├ļĪó╚šę╣╣źĻPĪŻ ĪĪĪĪį┌ėąą¦╦Ä╬’čą░lĘĮ├µŻ¼ĘeśO═Ųäė┴ū╦ß┬╚ÓŁĪóÜõč§╗ņ║Ž╬³╚ļÜŌĄ╚ęÄĘČąį╩╣ė├Ż¼╠ßĖ▀Š╚ų╬─▄┴”ĪŻĘeśO═Ųäėųą╦Äė├ė┌┼R┤▓ų╬»¤Ż¼“Ę╬čū1╠¢”│²į┌╚½╩ĪČ©³cßtį║╩╣ė├═ŌŻ¼▀ĆŽ“║■▒▒╩Ī10╝ęßtį║ŠĶ┘ø2.6╚f░³ĪŻ ĪĪĪĪį┌ę▀├ńčą░lĘĮ├µŻ¼ĮM┐ŚČÓ╝ę┐ŲčąÖCśŗĪóŲ¾śI▓óąąķ_š╣Ž┘▓ĪČŠ▌d¾wę▀├ńĪóųžĮMĄ░░ūę▀├ńĪómRNAę▀├ńĄ╚čą░lŻ¼╚ĪĄ├ļAČ╬ąį▀Mš╣Ż¼├Ōę▀äė╬’«a╔·┴╦┐╣¾wŻ¼▓┐Ęųę▀├ń╝┤īó▀M╚ļäė╬’╣źČŠ▒Żūoįć“×║═░▓╚½ąįįuārĪŻ ĪĪĪĪį┌Öz£yį\öÓ«aŲĘčą░lĘĮ├µŻ¼─┐Ū░ć°╝ęęčīÅ┼·═©▀^Ą─16ĒŚÖz£yįćä®ųąŻ¼ÅV¢|š╝┴╦5ĒŚŻ╗▀Ćėą5╝ęå╬╬╗čą░lĄ─8éĆÖz£yįć䮫aŲĘęč╝{╚ļæ¬╝▒īÅ┼·═©Ą└ĪŻ ĪĪĪĪĘ└ūo╬’┘YĄ─čą░l╔·«aŻ¼╩ŪÅV¢|ū„×ķųŲįņśI┤¾╩ĪĄ─ÅŖĒŚĪŻ²Åć°ŲĮ═Ė┬ČŻ¼ÅV¢|╩ĪęčĮøčą░l│÷ČÓ┐Ņ┐╔ųžÅ═╩╣ė├Ą─├±ė├┐┌šųŻ¼╚ńėąÖC╣Ķ═ķ┐┌šųĪóųžļxūė×V─ż┐┌šųĪóŠ█╦─Ę·ęꎮ×V─ż┐┌šųĪó╝{├ūŃy┐╣Š·┐┌šųŻ¼ĮøŽÓĻPÖCśŗÖz£yŻ¼┐╔▀B└m╩╣ė├7╠ņęį╔ŽŻ¼ØMūŃ╔ńĢ■ąĶŪ¾ĪŻ ĪĪĪĪÅVų▌┐Ų╝╝æ“ę▀”│╔╣¹ ĪĪĪĪ1 ĪĪĪĪACE2╚╦į┤╗»ąĪ╩¾Ż║ųŲū„ą¦┬╩┤¾Ę∙ŅIŽ╚ć°ļH ĪĪĪĪÅVų▌į┘╔·ßtīW┼cĮĪ┐ĄÅV¢|╩ĪīŹ“×╩ęĄ─ģŪ╣Ō├„蹊┐åTĮķĮBŻ¼ą┬╣┌▓ĪČŠ╩Ū═©▀^ę╗ĘN├ĖŻ©║åĘQACE2Ż®üĒĖą╚Š╚╦ŅÉŻ¼ąĪ╩¾ę▓ėą▀@ĘN├ĖŻ¼ų╗╩Ū║═╚╦Ą─ėą▒╚▌^┤¾Ą─▓Ņ«ÉŻ¼ī¦ų┬ąĪ╩¾ī”ą┬╣┌▓ĪČŠ▓╗ęūĖąĪŻ═©▀^▐D╗∙ę“Ą─ĘĮĘ©┐╔ęįį┌ąĪ╩¾▒Ē▀_╚╦Ą─ACE2Ż¼┐╔ęį▌^┐ņ½@Ą├ęūĖąąĪ╩¾ĪŻ ĪĪĪĪ“╬ęéāłFĻĀÅ─1į┬31╚š╠ß│÷ĘĮ░Ėķ_╩╝Ż¼ĄĮ3į┬6╚š╚╦į┤╗»ąĪ╩¾│÷╔·Ż¼āHė├┴╦35╠ņĪŻīŹļH╔ŽŻ¼═©▀^┼▀╠źĖ╔╝Ü░¹ųŲū„ąĪ╩¾─Żą═Ą─╝╝ągęčĮø║▄│╔╩ņŻ¼╬ęéāų«╦∙ęį─▄▀@├┤┐ņŻ¼ų„ę¬╩Ūę“×ķ╝ė╚ļ┴╦╬ęéā¬ÜėąĄ─╦─▒Č¾wčaāö╝╝ągŻ¼╬ęéāė├įō╝╝ągųŲū„ąĪ╩¾Ą─ą¦┬╩┐╔ęį▀_ĄĮ30%-60%Ż¼ŅIŽ╚ć°ļH╔Žł¾Ą└Ą─1%-2%Ą─ŲĮŠ∙│÷╔·┬╩ĪŻĖ³ųžę¬Ą─ę╗³c╩ŪŻ¼┼▀╠źĖ╔╝Ü░¹╝╝ąg┼c╦─▒Č¾wčaāö╝╝ągŽÓĮY║Ž║¾Ż¼┐╔ęį═¼śė┐ņ╦┘Ė▀ą¦ųŲéõŲõ╦¹╚╦į┤╗»ąĪ╩¾─Żą═Ż¼ī”Į±║¾═╗░l╩┬╝■æ¬╝▒╣źĻPŠ▀ėąųžę¬ęŌ┴xĪŻ”ģŪ╣Ō├„šfŻ¼įōąĪ╩¾╩Ū蹊┐ą┬╣┌▓ĪČŠĖą╚ŠÖCųŲĪó╦Ä╬’║Y▀x║═ę▀├ńķ_░lĄ╚ŅIė“Ą─└ĒŽļäė╬’─Żą═Ż¼ėąų·ė┌ĮŌøQ«öŪ░╚▒Ę”ėąą¦Ą─ęÄ─Ż╗»Ą─ą┬╣┌Ę╬čūäė╬’─Żą═Ą─└¦Š│ĪŻ (ž¤╚╬ŠÄ▌ŗŻ║Doctor001) |